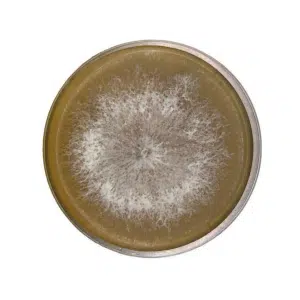
Round petri dish with white, fuzzy mould colony growing on brown agar medium, viewed from above.

Amongst our clients:
We also serve a diverse range of professionals including landscapers, environmental consultants, artists, designers, and mushroom cultivators.
A fun, interactive method that produces generous yields while offering a true hands-on experience. It takes a little setup and sourcing of materials, but it’s ideal for beginners wanting to dive into mushroom growing.
Our growing kits include everything you need to learn the full mushroom cultivation process. They don’t produce large harvests, but are perfect for understanding each stage from start to finish.
Super simple – just choose the mushroom variety suited to your climate, spray with water, and watch it grow. It’s the easiest, fastest, and most beginner-friendly way to start growing mushrooms at home.

Curious about the latest mushroom trends? Discover what fungi enthusiasts are cultivating in their homes and gardens. From oyster mushrooms to shiitake, we’ll share popular blogs showcasing the mushrooms people are growing right now. Whether you’re a beginner or an experienced grower, you’ll find inspiration and tips from fellow mushroom lovers. Stay up-to-date with the most exciting varieties and learn why these particular mushrooms are capturing everyone’s attention.
This section is changed seasonally to include top varieties people are growing and how to guide.
Your Australian Mycology Supplies Store
Shopping list curated for Beginners
$35.00 – $500.00Price range: $35.00 through $500.00
Enjoy the finest selection of fresh, locally grown mushrooms from Rootlab. As one of the leading producers supplying restaurants, grocers, and our own in-house supplement line, we take pride in cultivating high quality varieties like Lion’s Mane, Reishi (Native), Turkey Tail, and Cordyceps, Maitake, Shiitake. We also reserve a portion of our harvest for local pickup from our Marrickville facility. Can’t find what you’re looking for? Get in touch with us and we’ll do our best to make it happen.
Rootlab offers a range of premium mushroom supplements made from freeze dried mushrooms. We also stock dehydrated mushrooms, available in both whole and powder form. We also produce capsules and tinctures, crafted for maximum potency and convenience. Rootlab is currently developing next generation mushroom based supplements tailored for business use, stay tuned for what’s coming next.
New to mushroom growing? Our easy-to-follow video series has got you covered. Learn all the essential skills you need to start your mycology journey. From identifying different mushroom types to setting up your growing space, we break down each step in simple terms. Watch as experts guide you through the basics of cultivation, care, and harvesting. Perfect for beginners, these videos will help you gain confidence in your mushroom-growing abilities. We’re gradually expanding our library, so check back regularly for new content as we continue to upload more instructional videos. Start your fungal adventure today!
Explore our range of mushroom growing products through our informative video showcase. Get up close and personal with our cultivation kits, tools, and accessories. These brief videos highlight key features, demonstrate proper use, and offer helpful tips to make your mushroom growing experience a success. Whether you’re interested in grow bags, substrate mixes, or specialized equipment, our product videos provide a clear look at what we offer. Watch now to find the perfect items for your mycology projects.
Subscribe for exclusive savings & first dibs on exciting updates. Be in the know – sign up now!
Subscribe for exciting updates about Plant Tissue Cultures. Be in the know – sign up now!